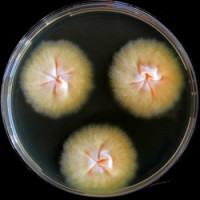
Houby si při šíření kožní infekce z morčat na člověka mohou pomáhat toxiny

Kontakt
Časopis CzechIndustry
STUDIO P+P s.r.o
Semilská 389/40
197 00 Praha 9
+420 602 363 969
+420 605 463 150 petruzalek.redakce@seznam.cz, redakce.k@seznam.cz
Semilská 389/40
197 00 Praha 9
+420 602 363 969
+420 605 463 150 petruzalek.redakce@seznam.cz, redakce.k@seznam.cz
František Petružalek © 2013 - 2020 Všechna práva vyhrazena.
- O nás
- Historie
- Ekonomika
- Ze zahraničí
- Zdraví
- Informujeme
- Zpravodajství
- Civilizace
- Styl
- Zrcadlo